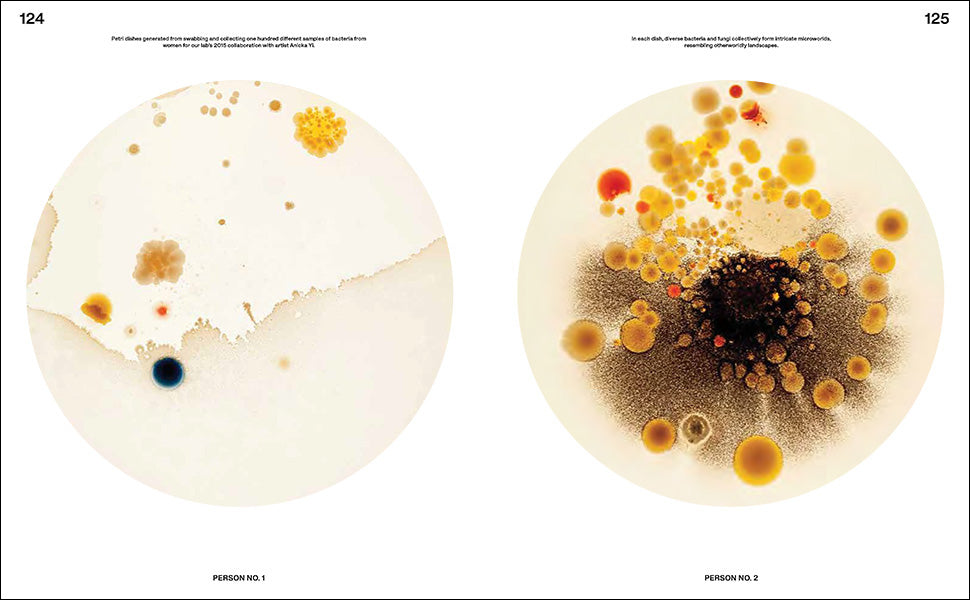

Home / Photography coffee table books / Beautiful Bacteria





Beautiful Bacteria
A breathtaking science coffee table book that redefines our understanding of microbes. This visually striking volume combines stunning imagery with engaging narratives, illuminating the intricate lives of bacteria we encounter daily.
Free shipping over $139
Free returns
Choose options

Dimensions
x x
Weight
Released
3/26/24
ISBN
9780847899869
Published by
Rizzoli Electa
Beautiful Bacteria
★★★★★
I'm obsessed with all the books I've purchased from Blank Canvas Bookstore. I love getting compliments from my friends on all the crazy awesome books I've collected!!
Ashley C.
★★★★★
Blank Canvas Bookstore is great. I love the variety of loud, colorful books.
Laura A.
★★★★☆
I unfortunately had an issue with my order but the person who resolved it was so helpful and nice!
Elizabeth B.





